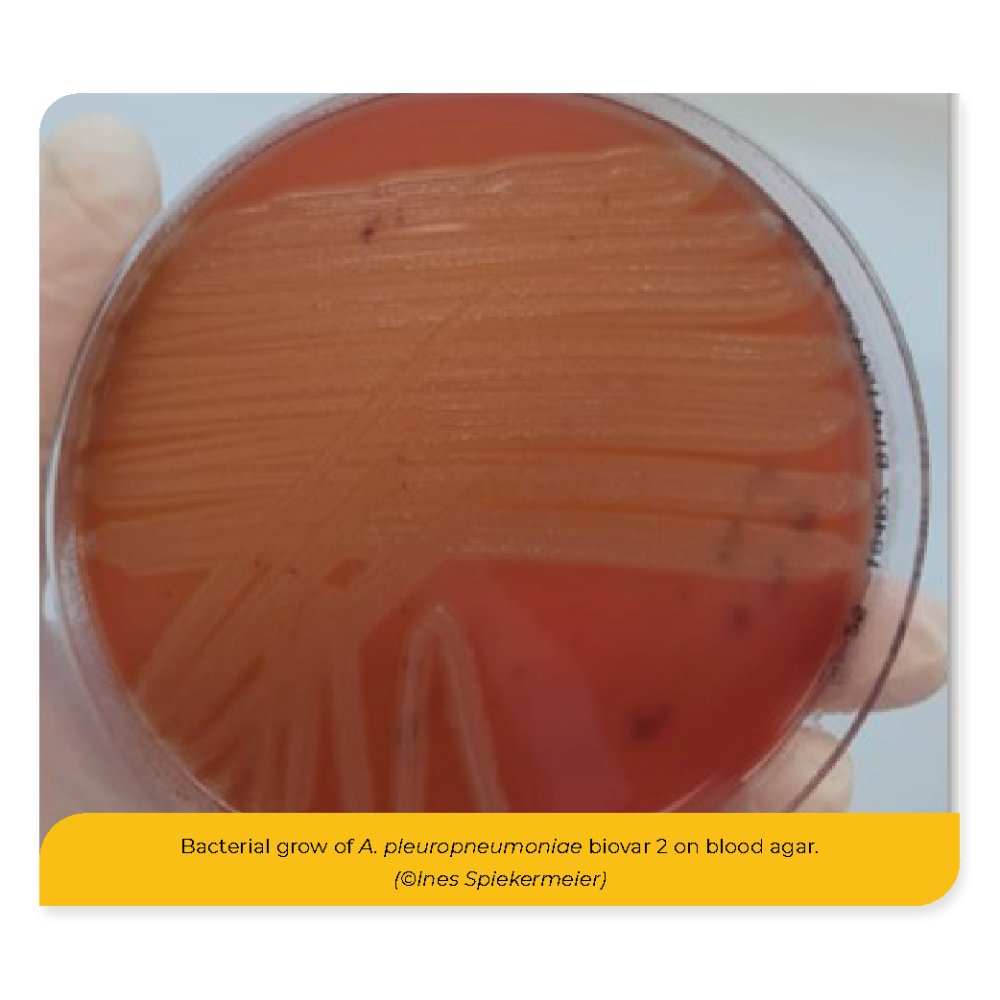

Case report of an unusual finding: A. pleuropneumoniae Serotype 2, Biovar 2 in a German pig farm
Background and Objective
Actinobacillus pleuropneumoniae (APP) is a causative agent of pleuropneumonia, resulting in considerable economic losses in the pig industry. Currently, 19 serotypes and 2 biovars of APP have been described, with geographical variations in their distribution and pathogenic relevance. In Germany, NAD-dependent biovar 1 is by far the predominant biovar while biovar 2 has a prevalence of around 0.5 % (Schuwerk et al. 2021).
The objective of this contribution is a respiratory case with fatal outcomes in the fattening unit of a German sow farm with 250 sows, resulting in a total mortality of 0.4 % and morbiditiy of 1 %.
Material and Methods
Lung samples were collected for further analysis and transferred to a lab (SAN Group Biotech Germany).
Standard aerobic bacteriological culture was carried out and the grown isolate was identified by MALDI-TOF mass spectrometry and 16S rRNA gene sequencing. Screening, serotyping and biovar determination, along with toxin profiling were conducted using PCR assays (KYLT APP, KYLT APP Typing, in house method). Additionally, screening PCRs for Influenza A (KYLT IVA beta RTU FLI-C 069), Porcine Reproductive and Respiratory Syndrome Virus (PRRSV) (KYLT PRRSV), and Actinobacillus suis (EXOone Actinobacillus suis) were conducted on the lung tissue samples.
Results
APP-specific PCR on lung tissue revealed a CT value of 19.1. PCR testing for Influenza A, whereby PRRSV and A. suis remained negative. The only pathogen isolated exhibited NAD-independent growth on blood agar. Subsequent MALDI-TOF analysis confirmed the species as Actinobacillus pleuropneumoniae. 16S rRNA gene sequencing of the isolate resulted in a 99.9 % identity to A. pleuropneumoniae. Serotyping and biotyping via gel-based and real-time PCR confirmed the presence of serotype 2, biovar 2. Further toxin profiling revealed positive results for ApxI and ApxII toxins (IVD Labor GmbH Hannover). In contrast to “classical” biovar 1 strains of serotype 2 of APP in Germany, the apxIICA and the apxIIIBD toxin for this specific strain were missing.

Discussion and Conclusion
To the best of our knowledge, this represents the first reported case of a respiratory disease caused by A. pleuropneumoniae serotype 2, biovar 2 in a German pig farm. Further research (including whole genome sequencing) is essential to understand the implications of this atypical strain on disease management and control strategies.
Schuwerk L., Hoelting D., Waldmann K.-H., Valentin-Weigand P., Rohde J.: Sero- and apx-typing of German Actinobacillus pleuropneumoniae field isolates from 2010 to 2019 reveals a predominance of serovar 2 with regular apx-profile. Vet Res. 2021 20:25(1).
Let’s talk solutions and connect with our corresponding author: ines.spiekermeier@san-group.com
Credits:
I. Spiekermeier1 , Birte Wegner2, Isabel Hennig-Pauka3
1 SAN Group Biotech Germany GmbH, Hoeltinghausen, Germany
2 Vetxperts Dümmerland, Steinfeld, Oldenburg, Germany
3 Field Station for Epidemiology (Bakum), University of Veterinary Medicine Hannover, Foundation, Germany
SAN Group Biotech Germany GmbH I Mühlenstraße 13. I 49685 Höltinghausen GERMANY I +49 4473 9438 0 I office-de@san-group.com
Contact:
Contact us using the following form.